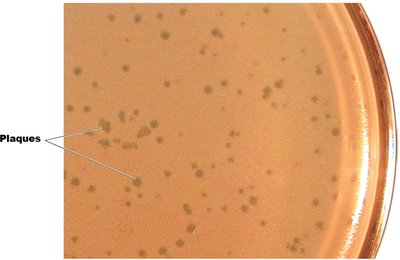
Viral plaques formed by bacteriophages

Back
BackViruses and Prions: Structure, Classification, Replication, and Pathogenicity
Study Guide - Smart Notes

Viruses and Prions
General Characteristics of Viruses
Viruses are unique infectious agents that differ fundamentally from cellular life forms. They are obligate intracellular parasites, meaning they require a living host cell to reproduce. Viruses can infect all forms of life, including animals, plants, bacteria, and archaea.
Obligate Intracellular Parasites: Viruses cannot multiply outside a host cell and must hijack the host's metabolic machinery for replication.
Genetic Material: Viruses contain either DNA or RNA, but never both. Their genomes can be single-stranded or double-stranded, linear or circular, and are much smaller than those of cells.
Structure: Viruses lack ribosomes, cytoplasmic membrane, cytosol, and organelles. They do not generate ATP and cannot carry out metabolic processes independently.
States: Viruses exist in two states: the extracellular state (virion) and the intracellular state (nucleic acid only).

Are Viruses Alive? The debate continues: some scientists consider viruses to be complex chemicals, while others view them as the simplest forms of life due to their ab ility to replicate and evolve within host cells.
Comparison of Viruses and Cells
Viruses and cells differ in several fundamental ways, as summarized in the following table:
Property | Viruses | Cells |
|---|---|---|
Metabolism | Inert outside a cell | Metabolize on their own |
Growth/Division | Do not grow or divide | Grow and divide |
Cellular Structure | Acellular | Cellular |
Genetic Material | DNA or RNA | Both DNA and RNA |
Size | 10 nm to 400 nm | 200 nm to 1 mm |
Replication | Assembly-line using host | Self-replicating |

Host Range and Specificity
The host range of a virus is the spectrum of host cells it can infect. Most viruses are highly specific, infecting only certain cell types within a single host species, determined by specific attachment sites and cellular factors. Some viruses, called generalists, can infect multiple hosts or cell types.

Size and Morphology of Viruses
Viruses are much smaller than most cells, typically ranging from 20 nm to 1000 nm. Their morphology can be classified as:
Helical: Hollow, cylindrical capsid (e.g., Ebola virus).
Polyhedral: Many-sided, often icosahedral (e.g., adenovirus).
Enveloped: Surrounded by a lipid envelope derived from the host cell membrane.
Complex: Complicated structures, such as bacteriophages with heads and tails.





Viral Structure
The basic structure of a virion includes:
Nucleic Acid: The viral genome (DNA or RNA).
Capsid: Protein coat made of subunits called capsomeres.
Envelope (optional): Lipid, protein, and carbohydrate layer surrounding some viruses.
Spikes: Surface projections that aid in attachment to host cells.

Taxonomy and Classification of Viruses
Viruses are classified based on their genetic material, structure, and host range. The taxonomy includes:
Family names: End in -viridae (e.g., Herpesviridae).
Genus names: End in -virus (e.g., Simplexvirus).
Species: Defined by genetic information and ecological niche; common names are used.
Subspecies: Designated by numbers.
Isolation, Cultivation, and Identification of Viruses
Viruses must be grown in living cells. Methods include:
Bacteriophages: Grown in bacterial cultures; form plaques on agar plates, each representing a single virus.
Animal Viruses: Grown in living animals, embryonated eggs, or cell cultures (e.g., HeLa cells).
Identification: Based on cytopathic effects, serological tests (antibody reactions), and nucleic acid analysis (PCR).

Viral Replication Cycles
Viruses replicate by taking over the host cell's machinery. The two main cycles in bacteriophages are:
Lytic Cycle: Virus replicates and lyses the host cell, releasing new virions.
Lysogenic Cycle: Viral DNA integrates into the host genome as a prophage, replicating with the host cell until induction triggers the lytic cycle.



Multiplication of Animal Viruses
The replication of animal viruses involves several steps:
Attachment: Virus binds to host cell membrane.
Entry: By receptor-mediated endocytosis or fusion.
Uncoating: Viral genome is released by host or viral enzymes.
Biosynthesis: Production of viral nucleic acids and proteins.
Maturation: Assembly of viral components.
Release: By budding (enveloped viruses) or cell rupture.
Biosynthesis of DNA and RNA Viruses
DNA Viruses: Replicate DNA in the nucleus, synthesize capsid in the cytoplasm.
RNA Viruses: Replicate in the cytoplasm using RNA-dependent RNA polymerase. Positive-sense RNA acts as mRNA; negative-sense RNA must be transcribed to positive-sense.
Retroviruses: Use reverse transcriptase to make DNA from RNA, which integrates into the host genome (e.g., HIV).
Viruses and Cancer
Some viruses can cause cancer by integrating oncogenes or activating host protooncogenes. Examples include:
DNA Viruses: Human papillomavirus (HPV), hepatitis B virus (HBV), Epstein-Barr virus (EBV).
RNA Viruses: Retroviruses such as HTLV-1 and HTLV-2.
Oncogenic viruses can transform normal cells into tumor cells, which may display tumor-specific antigens.
Latent and Persistent Viral Infections
Latent Infections: Virus remains dormant in host cells and can reactivate (e.g., herpes simplex, varicella-zoster).
Persistent Infections: Virus is continuously released over a long period, often leading to chronic disease (e.g., HIV, hepatitis B).
Prions: Infectious Proteins
Prions are infectious proteins that cause neurodegenerative diseases known as spongiform encephalopathies. They lack nucleic acids and are highly resistant to standard sterilization.
Diseases: Creutzfeldt-Jakob disease, mad cow disease (BSE), Kuru, fatal familial insomnia, sheep scrapie.
Mechanism: Prion proteins (PrP) induce normal proteins to misfold into the disease-causing form, leading to brain damage.
Transmission: Ingestion, transplantation, or contact with infected tissues.
Combating Prions: Prions are destroyed by incineration or autoclaving in concentrated sodium hydroxide; normal sterilization is ineffective.
